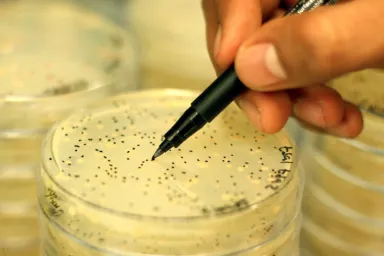

Automation: the path to consistency
Reproducibility is the cornerstone of credible scientific research – especially in assays as foundational as the colony formation (clonogenic) assay. This assay is universally regarded as a gold-standard for measuring how cancer cells survive treatments like radiation or chemotherapy. In a typical clonogenic assay, cells are seeded at low density, exposed to a treatment, and then allowed time to form colonies from surviving cells. Researchers count these colonies to determine the treatment’s effect on cell viability.
The challenge? Counting cell colonies has traditionally been a tedious and time-consuming manual task. It’s not just laborious – it’s inherently prone to human error and to unintended bias. Cutting out sources of variability in the colony detection workflow is absolutely key to reproducibility and objectivity in the analysis of colony formation assays.
Manual colony counting is laborious, with consistency difficult to achieve due to fatigue and bias. Counting dozens of plates by eye is not only slow but also error-prone, as concentration inevitably fluctuates.
Labs often lean on a single well-trained person to process colony assays as an approach to minimize variation. However, this is not a solution that scales well.
And then there is the lack of standardized criteria. Without an objective definition of what “counts” as a colony (size, shape, minimum cell number, etc.), each lab, or each scientist, is free to apply different ground rules. The classic clonogenic assay has no external calibration standards, so comparing results across experiments or labs can be like comparing apples and oranges. These factors make reproducibility challenging. A manual counting scenario that might be “good enough” for a small pilot experiment can become a liability in larger studies where consistency (and/or throughput!) are critical.
The rise of more complex assay formats has only amplified this limitation. Modern cancer research is increasingly embracing 3D culture models – spheroids, organoids, colonies in soft agar, etc. For the same number of cells these objects are much smaller and thus even harder to count manually, typically requiring detection under a microscope. Since 3D colonies are usually immobilized in semi-solid media such as methylcellulose or soft agar and are therefore spread both in the x/y AND in the z-plane, this makes manual colony detection on any scale almost impossible.
Pitfalls of manual colony counting include:
If manual counting is the bane of colony counting, the obvious solution is to take the human (i.e., fatigue and bias) out of the equation as much as possible.
Enter automated colony counting systems. Automation in colony formation assays isn’t new per se – semi-automated image analysis methods have been explored for years – but today’s dedicated instruments have truly changed the game. Modern automated colony counters are fully integrated systems that use high-resolution imaging and intelligent software algorithms to detect and count colonies objectively.

Automation provides the elusive objectivity we need – every plate is analyzed with the same unbiased eye, whether it’s 50 colonies or 500. By eliminating subjective judgment calls, automated counters eliminate human bias and error, leading to far more reproducible data.
Speed and throughput are additional bonuses that feed back into reproducibility. A modern colony counter can image four 6-well plates in around 5 minutes outputting colony counts and additional colony parameters such as colony size statistics as a free bonus.
With such speed, researchers are empowered to run larger experiments or more replicates, which improves the statistical robustness.
Gone is the pressure to process a quadrant of a dish and to simply multiply the result (a common shortcut with manual colony counting). Higher throughput also means experiments can be repeated more easily, which again supports reproducibility.
In short, automation addresses the root causes of variability inherent in manual processing of colony assays and provides a host of highly valuable additional benefits.
Machine counting transforms colony counting from an art (prone to personal interpretation) into more of a science that yields the same result no matter who, when, or where it’s done. As one industry article succinctly put it, using automated counters improves count accuracy, eliminates user fatigue, and saves time, all while providing “sustained reproducibility across experiments.”
The GelCount™ system by Oxford Optronix is a dedicated colony counter that cancer research labs worldwide have relied on for years. The GelCount has became an industry standard device, with over 500 peer-reviewed publications citing its use.

GelCount 2 builds upon all the strengths of the original but adds a refreshed design, 30-50% faster imaging, a substantially improved user interface and software experience, and support for Ibidi® 15-well 3D chamber slides.
The colony formation assay is essential for understanding cancer treatment responses, and with hundreds of systems already in use worldwide and 500+ citations to its name, the GelCount has played a crucial role in advancing cancer research. Now GelCount 2 is “elevating it” further.
Reproducibility in colony formation assays has historically been difficult to achieve due to the inherent variability of manual counting. By embracing automated counting solutions like the GelCount 2, researchers can dramatically improve the reliability of their clonogenic assay results.
Automation provides the consistency that humans simply can’t maintain hour after hour, plate after plate. The result is data that you can trust.
On a practical level, removing the drudgery of manual counting frees up valuable time and can improve lab morale!
It’s a win-win: greater efficiency and throughput, better results and happier researchers.
In moving from variability to consistency through automation, the colony formation assay is getting a new lease of life. What was once a tedious technique is becoming a streamlined, high-throughput and reliable assay for quantifying cell survival.
Ihre Wahl bezüglich Cookies auf dieser Seite. Für weitere Informationen zu den von uns verwendeten Cookies, lesen Sie bitte unsere Privacy Policy